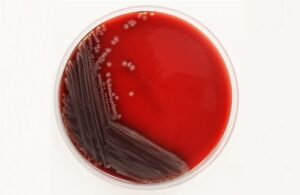
محیط کشت بلاد آگار چیست؟

فیلتر ممبران آزمایشگاهی و انواع و کاربردهای آن
فیلتر ممبران چیست و چگونه کار میکند؟ فیلتر ممبران (Membrane Filter) یک لایه نازک پلیمری با منافذ بسیار ریز است. این منافذ بهطور کنترلشده طراحی میشوند تا تنها ذرات کوچکتر از اندازه مشخص عبور کنند. ادامه مطلب